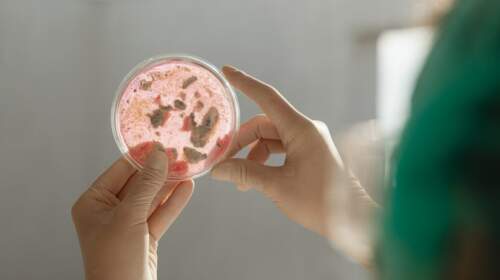

Παγώνη: «Δύσκολη η κλινική κατάσταση» Δεκάδες κρούσματα γαστρεντερίτιδας αντιμετώπισε το νοσοκομείο Χανίων. Δείτε επίσης: Κρήτη: Στο νοσοκομείο πάνω από 40 άτομα με συμπτώματα γαστρεντερίτιδας – Φοιτητές οι περισσότεροι Σύμφωνα με τον πρόεδρο της ΠΟΕΔΗΝ, Μιχάλη Γιαννακό, από προχθές το βράδυ μέχρι χθες το πρωί προσήλθαν στα Επείγοντα το νοσοκομείου 43 άτομα από τα οποία τα 23 παιδιά 18 έως 23…
Read MoreΣάββατο, 14 Δεκεμβρίου, 2024